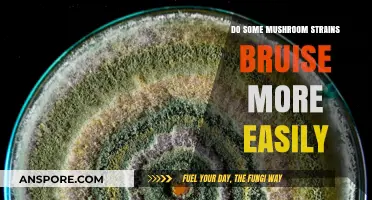
Mushroom Strains: Why Do Some Bruise More Easily?

Shiitake mushrooms are native to East Asia and have been used in traditional Chinese medicine and Japanese, Korean, and Eastern Russian medicine for centuries. They are also widely consumed as food. They are rich in flavour and nutrients, including vitamins, minerals, antioxidants, and amino acids. But do shiitake mushrooms contain vitamin C?
| Characteristics | Values |
|---|---|
| Do shiitake mushrooms have vitamin C? | No clear evidence |
| Vitamin D content | Shiitake mushrooms contain vitamin D2, a less beneficial form compared to vitamin D3 found in animal foods. |
| Other vitamins | Shiitake mushrooms are a source of vitamin B5, vitamin B6, and other B vitamins. |
| Minerals | Shiitake mushrooms contain copper, selenium, and potassium. |
| Antioxidants | Shiitake mushrooms contain ergothioneine, an antioxidant that prevents or slows cellular damage. They also contain choline, which has benefits for muscle movement, learning, and memory. |
| Amino acids | Shiitake mushrooms contain amino acids similar to those found in meat. |
| Health benefits | Shiitake mushrooms may have anti-cancer properties, boost immunity, support heart health, and improve circulation. |
| Side effects | In rare cases, shiitake mushrooms may cause skin rashes, digestive problems, and increased sensitivity to sunlight. |
| Culinary uses | Shiitake mushrooms are prized for their rich, savory, and earthy flavor. They are commonly used in stir-fries, risottos, soups, and as a topping for beef dishes. |
Explore related products
$20.99 $28.33
What You'll Learn

Shiitake mushrooms are rich in vitamin B6
Shiitake mushrooms are native to East Asia and have been used in traditional Chinese medicine as well as the medical traditions of Japan, Korea, and Eastern Russia. They are also a popular ingredient in Asian cuisine. In addition to their rich, earthy flavor and health benefits, shiitake mushrooms are an excellent source of vitamin B6.
Vitamin B6, also known as pyridoxine, is a water-soluble vitamin that plays a crucial role in various bodily functions. It is involved in protein metabolism, the creation of red blood cells, and the proper functioning of the nervous system. Vitamin B6 also contributes to the regulation of sleep patterns and the production of neurotransmitters, which are essential for maintaining good mental health.
Shiitake mushrooms are a rich source of vitamin B6, providing 104% of the daily recommended intake per cup, based on a 2,000-calorie diet. This makes them an excellent choice for individuals looking to boost their vitamin B6 intake. Vitamin B6 is also known to support heart health, reduce the risk of prostate cancer, aid in managing gingivitis, and boost the immune system.
By incorporating shiitake mushrooms into your diet, you can easily increase your vitamin B6 consumption. They can be used in a variety of dishes, such as stir-fries, risottos, and soups. Their savory flavor and meat-like texture make them a versatile ingredient that can enhance the taste and nutritional profile of your meals.
In addition to vitamin B6, shiitake mushrooms offer other nutritional benefits, including fiber, protein, carbohydrates, and various vitamins and minerals. They are also a source of vitamin D, which is important for maintaining bone health. Overall, shiitake mushrooms are a nutritious and flavorful addition to any meal, offering a range of health benefits beyond their rich content of vitamin B6.
Mushroom-Inspired Creativity: Will Wright's Journey
You may want to see also

They are also a source of vitamin D
Shiitake mushrooms are a source of vitamin D2, which is an inferior form of vitamin D3, found in fatty fish and some animal foods. Vitamin D is essential for building strong bones, and the human body needs it to absorb calcium.
Mushrooms are the only natural plant source of vitamin D. The vitamin D content in mushrooms varies depending on how they are grown and prepared. For example, when exposed to UV light, they develop higher levels of vitamin D. Shiitake mushrooms exposed to sunlight for two days, six hours per day, showed a significant increase in vitamin D levels, soaring from 100 IU/100 grams to nearly 46,000 IU/100 grams.
The vitamin D levels in shiitake mushrooms can also be increased by using a commercial pulsed UV lamp. One study showed that nutritionally relevant concentrations of vitamin D2 (10 μg/100 g FW) in whole mushrooms were effectively achieved within a very short time using this method. Another study found that the optimum conversion of ergosterol to vitamin D2 in shiitake mushrooms occurred at 35°C and 78% moisture, producing approximately 50 μg/g DW.
Shiitake mushrooms have been used in traditional Chinese medicine and are also part of the medical traditions of Japan, Korea, and Eastern Russia. They are believed to boost health and longevity and improve circulation. In addition, shiitake mushrooms are a good source of fibre, B vitamins, and minerals such as copper. They also contain polysaccharides, terpenoids, sterols, and lipids, which have immune-boosting, cholesterol-lowering, and potential anticancer effects.
Mushroom Lovers: Where to Buy Oyster Mushrooms?
You may want to see also

They may help fight cancer
Shiitake mushrooms are native to East Asia and have been used in traditional Chinese medicine for hundreds of years. They are also part of the medical traditions of Japan, Korea, and Eastern Russia. In Chinese medicine, shiitake are thought to boost health and longevity, as well as improve circulation.
Studies suggest that some bioactive compounds in shiitake may protect against cancer and inflammation. Lentinan, a polysaccharide extracted from shiitake, may help extend the survival of patients with some cancers when used with chemotherapy. However, one clinical trial showed that shiitake extract alone was not an effective treatment for prostate cancer. In addition, a polysaccharide/oligosaccharide complex from a shiitake extract also failed to show effectiveness in treating prostate cancer.
Furthermore, Latcripin-1 treatment, derived from shiitake, caused a dose-dependent decrease in the expression of the antiapoptotic protein Bcl-2. This suggests that Latcripins may reduce cancer cell survival, invasion, and migration. Similar results were observed with Latcripin-4 and Latcripin-11, which exhibited anticancer activity without causing any toxicity to HUVEC (Human Umbilical Vein Endothelial cells).
A combination of the standardized cultured extract of shiitake mycelia and Wasabia japonica, called Bioactive Immunomodulatory Compound (BAIC), demonstrated reduced viability of breast and pancreatic cancer cells.
While the potential anticancer properties of shiitake mushrooms are promising, more research is needed to validate these effects and establish shiitake as a useful adjunct to cancer treatment. Most studies on mushrooms and cancer have been conducted in Asia, so it is unclear if the same results would be seen in other populations.
Reishi Mushrooms: How Do They Work?
You may want to see also
Explore related products

They can improve heart health
Shiitake mushrooms are rich in selenium, vitamins, and other antioxidants, which help combat oxidative stress and inflammation in the cardiovascular system. By reducing oxidative damage to blood vessels and heart tissues, shiitake mushrooms support vascular health and overall heart function.
Studies have shown that the antioxidant properties of shiitake mushrooms contribute to their ability to protect against cardiovascular diseases and improve heart health outcomes. A study in lab rats fed a high-fat diet demonstrated that those given shiitake developed less fat in their livers, less plaque on their artery walls, and lower cholesterol levels than those that didn’t eat any mushrooms. The beta-glucans in shiitake mushrooms contribute to cholesterol reduction by inhibiting cholesterol absorption in the gut and enhancing its excretion from the body. These bioactive compounds help lower LDL ("bad") cholesterol and promote HDL ("good") cholesterol, thereby reducing the risk of heart disease.
Shiitake mushrooms have long been used in traditional Chinese medicine, as well as in Japan, Korea, and Eastern Russia. In Chinese medicine, shiitake are thought to boost health and longevity and improve circulation.
To improve your heart health, you can include shiitake mushrooms in your regular meals. Add them to stir-fries, soups, salads, or enjoy them as a flavourful side dish.
Mushrooms: A Unique Kingdom of Their Own
You may want to see also

They can be used to treat auto-immune diseases
Shiitake mushrooms are a popular food ingredient, native to Japan and China. They are also used in traditional Chinese medicine and are part of the medical traditions of Japan, Korea, and Eastern Russia. In these cultures, shiitake mushrooms are believed to boost health and longevity, as well as improve circulation.
Shiitake mushrooms contain a chemical called lentinan, which might stimulate the immune system. This suggests that shiitake mushrooms could be used to treat auto-immune diseases. However, it is important to note that there is conflicting evidence about the impact of shiitake mushrooms on auto-immune diseases. While some sources suggest that shiitake mushrooms might cause the immune system to become more active, which could increase the symptoms of auto-immune diseases, others suggest that the anti-inflammatory and immunomodulatory properties of shiitake mushrooms can help manage symptoms of auto-immune diseases, such as rheumatoid arthritis (RA).
RA is an autoimmune disorder characterised by chronic inflammation of the joints. Medicinal mushrooms, including shiitake, have anti-inflammatory and antioxidant properties, which can support overall immune health and potentially slow disease progression. Additionally, maitake mushrooms, a type of shiitake, contain a polysaccharide called D-fraction, which has been shown to help reduce inflammation and pain in RA patients, improving their quality of life.
While the immunomodulatory virtues of medicinal mushrooms offer therapeutic value in the treatment of immune conditions, it is important to consult a medical professional before using shiitake mushrooms to treat any health condition, especially auto-immune diseases.
Mushroom Omelette: Avoiding the Soggy Trap
You may want to see also
Frequently asked questions
No, shiitake mushrooms do not contain vitamin C. However, they are a source of vitamin D, B vitamins, potassium, and fibre.
Vitamin D helps the body absorb calcium and maintain strong bones and teeth. It also supports a healthy immune system, helps regulate mood, and may help prevent certain chronic diseases.
Shiitake mushrooms are nutrient-dense and contain dietary fibre, antioxidants, minerals, and vitamins. They are also a source of vitamin D, which may improve bone density. Studies suggest that some bioactive compounds in shiitake mushrooms may protect against cancer and inflammation.